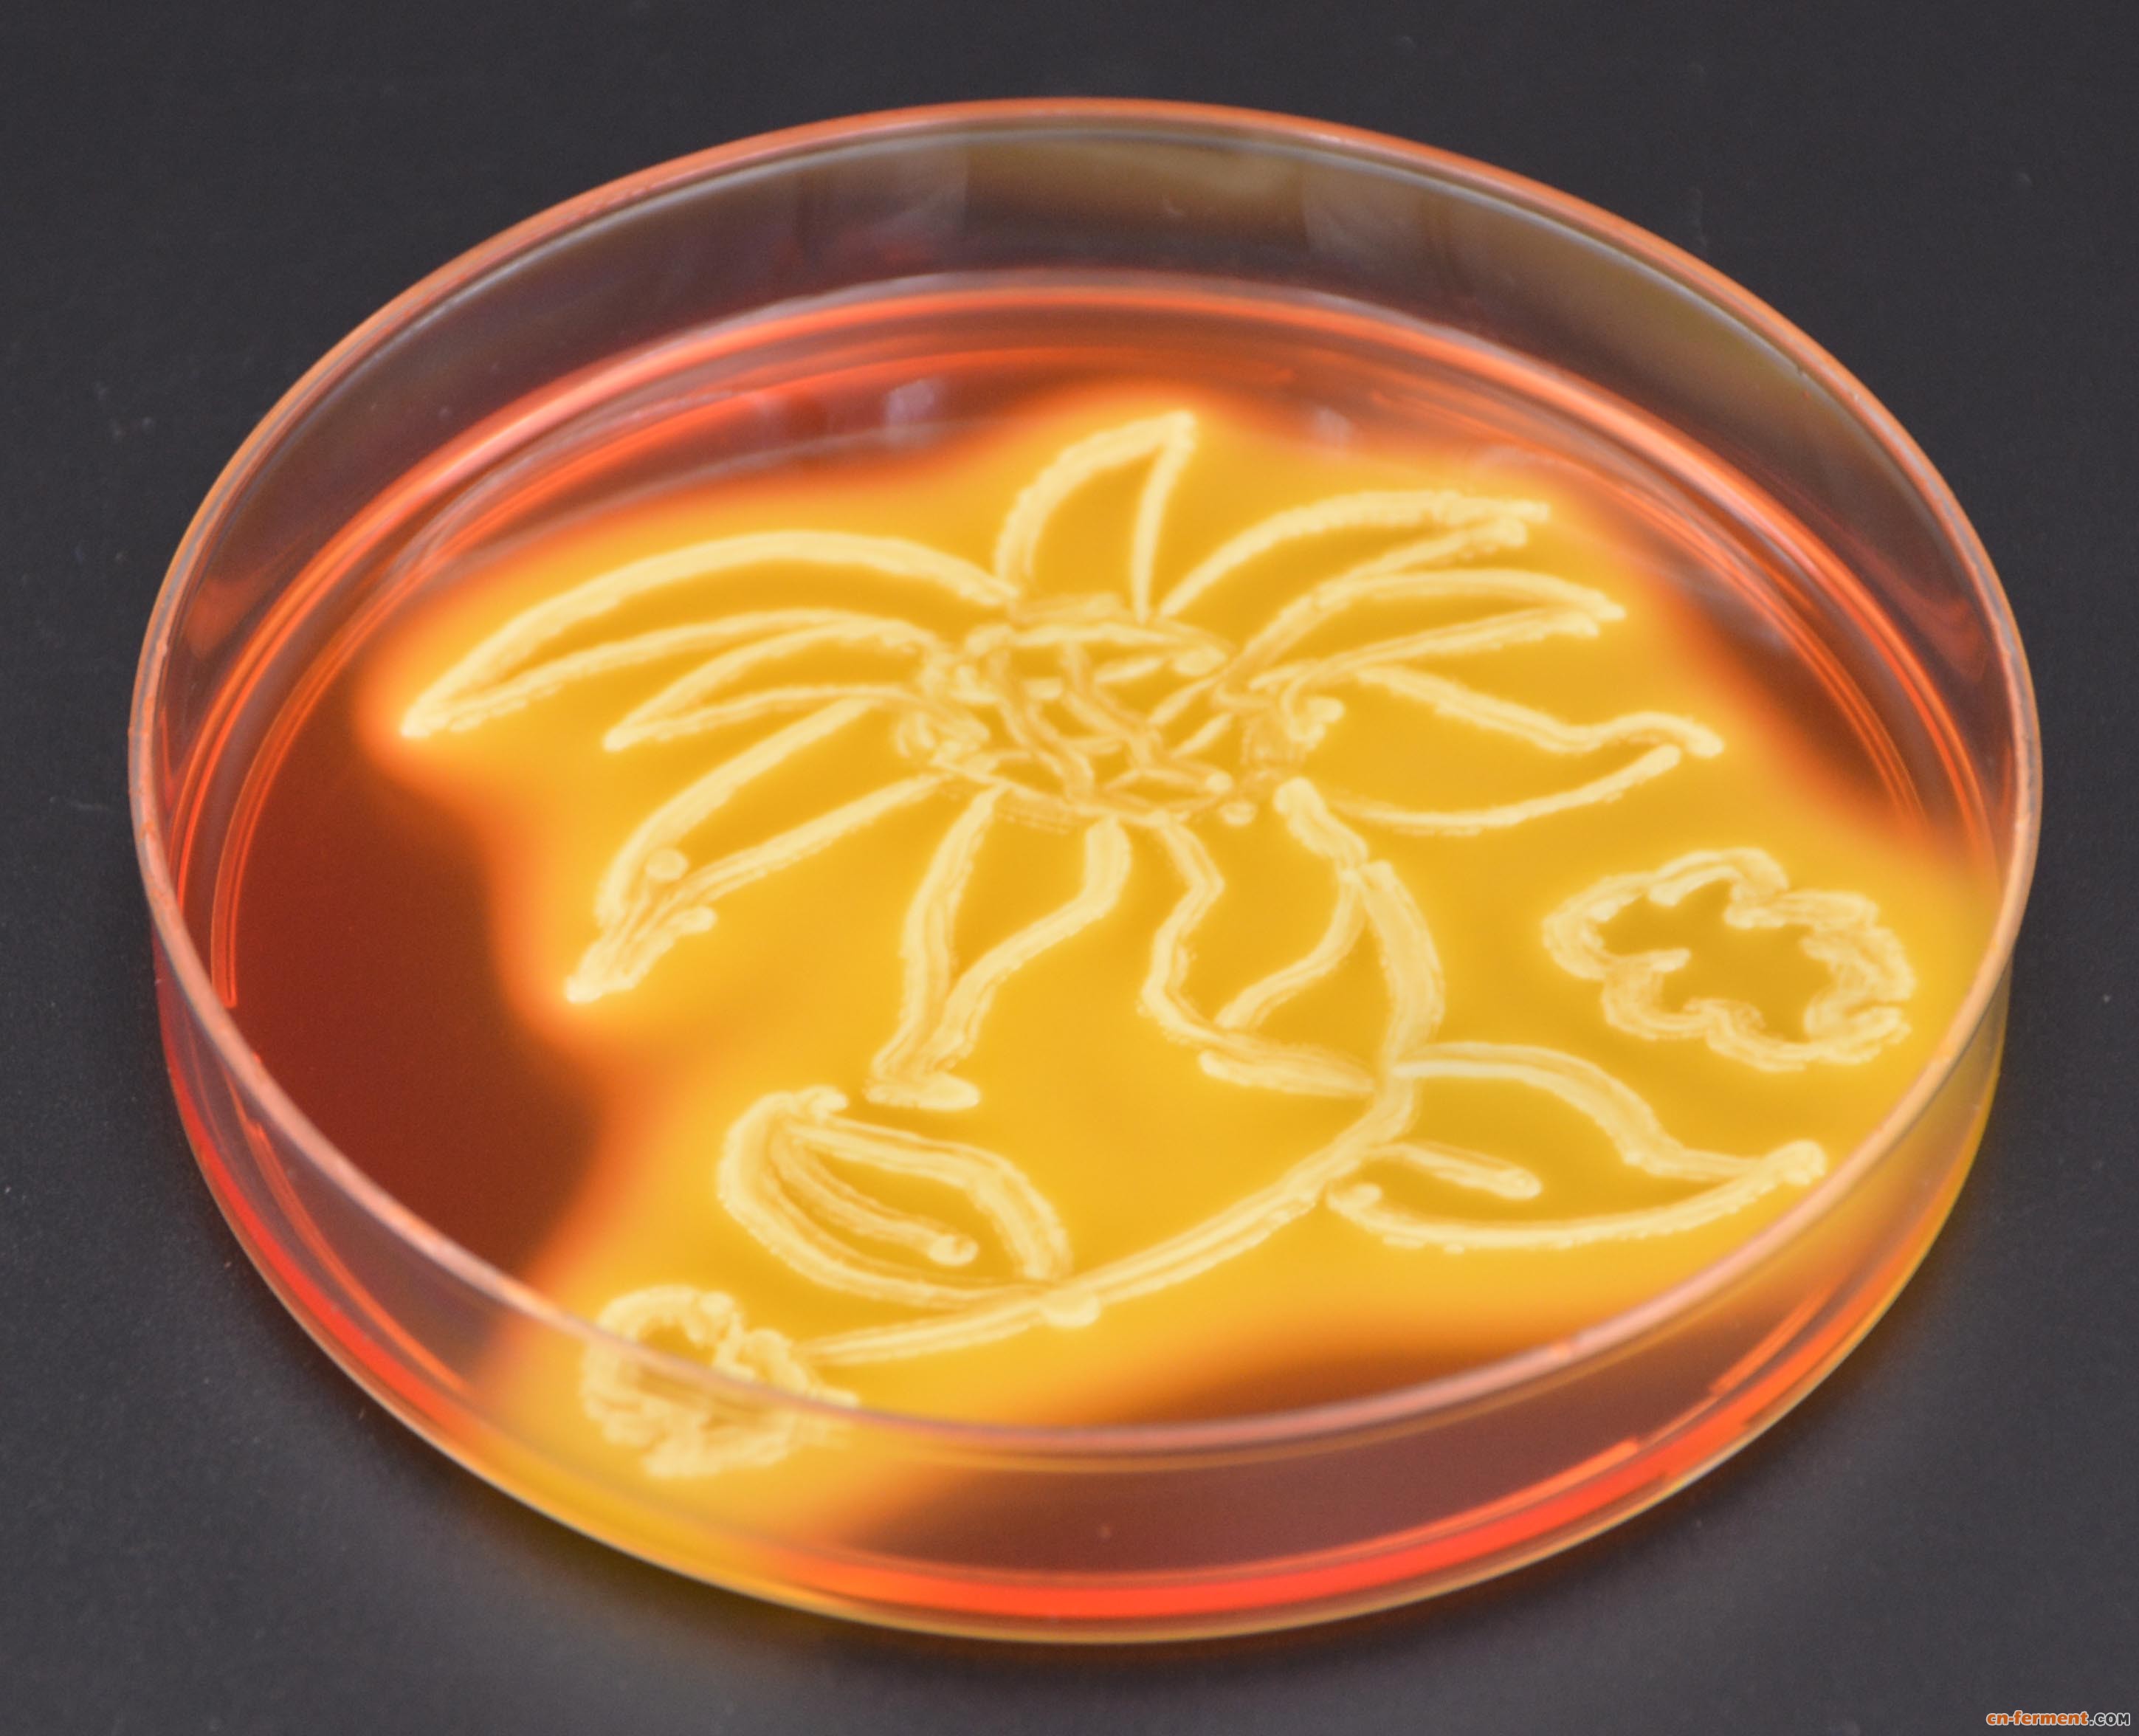
培养皿绘画 | 中国风劲吹,坐等大神挑战骏马图_新闻中心_安琪酵母股份

酵母培养皿

酵母培养皿
图片尺寸400x533
酵母,大群动物,个性,皮氏培养皿,显微镜
图片尺寸1200x800
清华大学生命科学学院戴俊彪博士在展示培养皿中的酿酒酵母菌株
图片尺寸400x266
酵母,大群动物,个性,皮氏培养皿,显微镜
图片尺寸1200x800
培养皿酵母菌,实验室微生物学教育.
图片尺寸1200x800
labware / plasticware / experimental instruments
图片尺寸1200x900
器皿里的酵母图片素材
图片尺寸500x500
鲁邦种发酵罐 酵种培养皿 刻度玻璃瓶天然酵母罐 做自己 味道自由
图片尺寸3024x3024
实验室培养培养皿上的酵母菌.
图片尺寸1200x800
培养皿中的耳念珠菌菌株.
图片尺寸640x687
而其他白色的污点则可能是葡萄球菌,橘色和黄色部分可能是酵母.
图片尺寸600x544
人类和酵母居然这么像
图片尺寸500x313
培养皿绘画 | 中国风劲吹,坐等大神挑战骏马图_新闻中心_安琪酵母股份
图片尺寸2898x2352
培养皿中的念珠菌菌落,隶属于酵母属(来源:nathan reading on visual
图片尺寸550x412
酵母培养物图片
图片尺寸300x300
酵种培养皿鲁邦发酵天然酵母玻璃密封储物刻度密封罐
图片尺寸800x800
kbd-120wg specific gravity, baume be degree,modu
图片尺寸1000x953
微生物学,酵母,实验室,皮氏培养皿,白喉
图片尺寸1200x800
c朱雀cc69
图片尺寸1000x750
需氧的,培养皿不密闭的,厌氧的,例如发酵的时候,酵母就是在密闭的瓶子
图片尺寸499x331